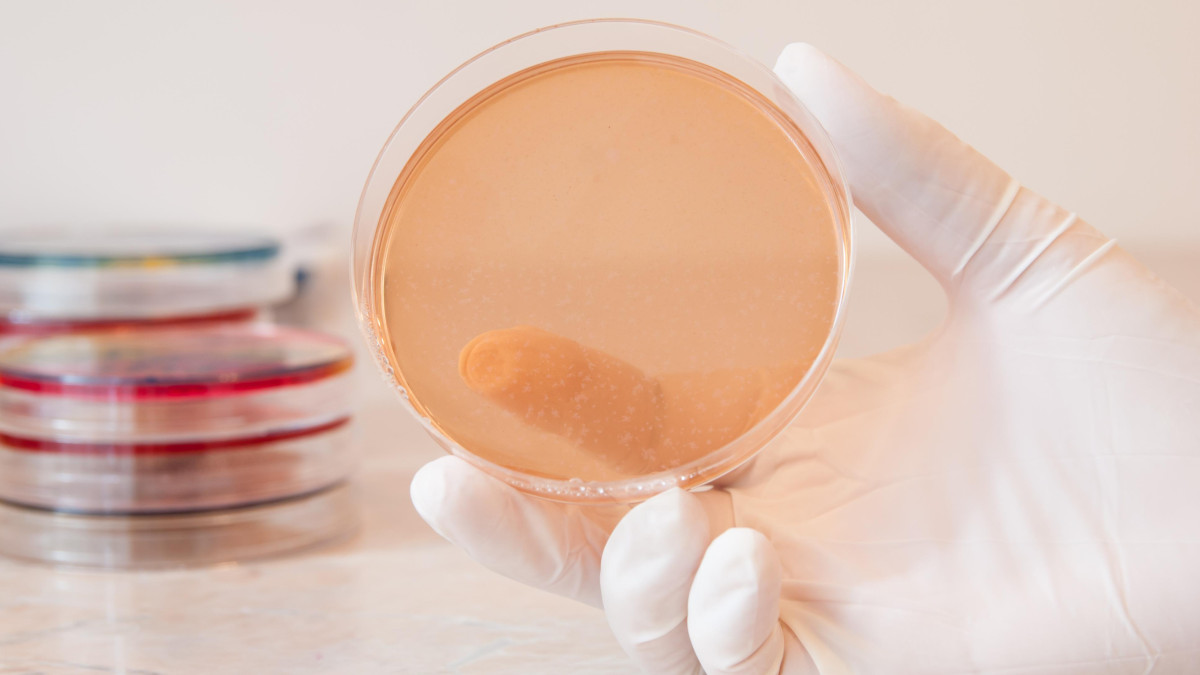
Salmonella zagrożeniem w Norwegii. Ogniska zakażeń w sześciu regionach

Salmonella zagrożeniem w Norwegii. Ogniska zakażeń w sześciu regionach
Do zakażenia doszło najprawdopodobniej w wyniku kontaktu z jednym produktem. Fot. Adobe Stock, licencja standardowa (zdjęcie poglądowe)
1) w Oslo,
2) w Vestfold og Telemark (2),
3) w Viken,
4) w Rogaland,
5) w Innlandet,
6) w Agder.
Wykryte baterie są genetycznie identyczne. – Wskazuje to na takie samo źródło zakażeń – precyzuje FHI.
Popularny produkt źródłem zakażeń?

Wykryty wariant to Salmonella Napoli. W przeszłości zidentyfikowano go w Norwegii tylko jeden raz.Fot. FDA [Public domain]
Źródła: FHI, MojaNorwegia.pl


Raport Norwegia
Twoje centrum aktualności i najnowszych wiadomości z Norwegii. Publikujemy dziesiątki informacji dziennie, abyś był zawsze na bieżąco. W jednym miejscu znajdziesz kluczowe informacje: od alertów pogodowych i sytuacji na drogach, przez doniesienia z rynku pracy, po najważniejsze wydarzenia z Oslo, Bergen, Stavanger i wszystkich regionów Norwegii.